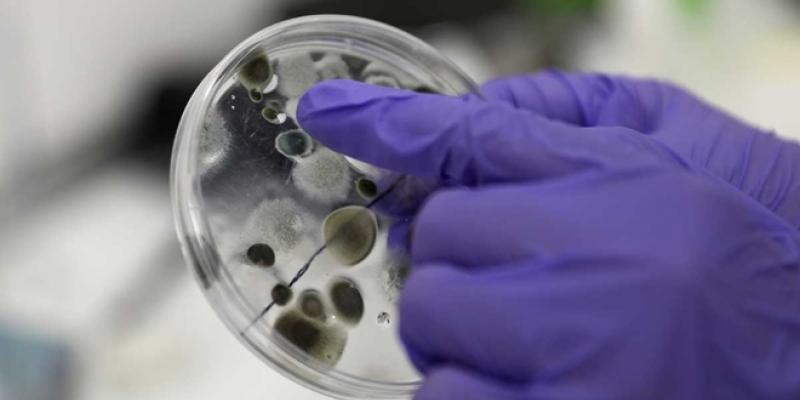
España suspende desde mañana la llegada de vuelos de Reino Unido y refuerza el control en Gibraltar

Lectura fácil
El Gobierno de España ha decidido, en coordinación con Portugal y ante la falta de posición común de la Unión Europea, “la suspensión de vuelos de entrada procedentes del Reino Unido desde mañana, salvo para ciudadanos españoles o residentes” por la nueva cepa de coronavirus descubierta.
España pone en cuarentena a Reino Unido por la nueva cepa
En la misma línea, Países Bajos, Bélgica, Italia y Austria han prohibido los vuelos con el Reino Unido después de que este país detectara una nueva cepa del nuevo coronavirus que le ha obligado a confinar de nuevo a más de 20 millones de personas.
Aunque Portugal y España estaban demandando una decisión conjunta a la Comisión Europea ante esta situación, desde Moncloa se ha traslado que la decisión de España se ha adoptado finalmente de manera concertada con Portugal y supondrá también un “reforzamiento de los controles en el paso fronterizo de Gibraltar”, ante la falta de decisiones por parte de la UE.
El presidente del Gobierno, Pedro Sánchez, ha mantenido una conversación sobre estas decisiones comunes con su homólogo portugués, Antonio Costa, tras la reunión del mecanismo de crisis de la Unión Europea, que hoy ha analizado los efectos de la nueva cepa del coronavirus detectada en el Reino Unido y ha pedido que se eviten los viajes no esenciales.
Medidas en el tráfico aéreo y controles en Gibraltar
Por ello, ambos ejecutivos han tomado esta medida, que en el caso de España ha decidido suspender desde mañana las entradas en territorio español de ciudadanos procedentes del Reino Unido, salvo nacionales españoles o residentes en España.
Además, el Gobierno recuerda que, para poder entrar en España, es obligatorio que todo pasajero procedentes de países o zonas en riesgo se realice una Prueba Diagnóstica de Infección Activa, PDIA, para SARS-Cov-2 en las setenta y dos horas previas a su llegada con resultado negativo.
De los países de la UE, el primero en reaccionar fue el gobierno de Países Bajos, que optó por prohibir el tráfico aéreo de pasajeros con el Reino Unido de forma inmediata y durante al menos diez días, siguiendo una recomendación de las autoridades sanitarias neerlandesas.
Bélgica, por su parte, ha instaurado la misma prohibición provisionalmente por solo 24 horas a partir de la medianoche del domingo, pero además del transporte aéreo incluye el ferroviario, ha indicado el primer ministro del país, Alexander De Croo, a la televisión pública flamenca VRT.
La nueva cepa de coronavirus detectada en Reino Unido
El pasado 14 de diciembre, el ministro británico de Sanidad, Matt Hancock, anunció que habían detectado una nueva variante del SARS-CoV-2, el coronavirus que causa la Covid-19. Fuentes británicas sospechan que esta cepa podría haber contagiado ya a más de un millar de personas en Reino Unido.
Al parecer, el problema de esta nueva cepa es la facilidad de su propagación. Borisn Johnson ha señalado que los expertos estiman que la nueva variante es un 70 % más transmisible que la original. El Ministerio de Sanidad británico cree que esta nueva variante de coronavirus puede estar asociada a la rápida propagación del virus en el sur de Inglaterra, aunque todavía se desconoce con certeza.



Añadir nuevo comentario